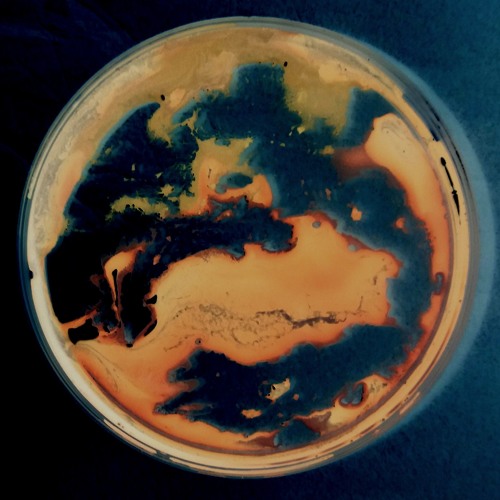

Recent comments
Calyx Kre
· 7moVery cool!!!!!!!!!!
NothinButDaBlues
· 5ybeautiful vibes going on here
Lizzie Taypen
· 5y@user-138663860: Ah thankyou Sandy....hope all is well, take…
GrevusAnjl
· 6yHypnotic soundscape, Lizzie. First song of the morning for m…









